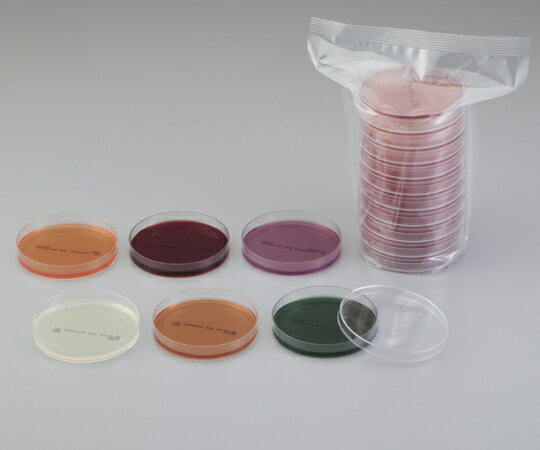
★ポイント最大16倍★【全国配送可】-生培地(バイタルメディア) DHL寒天培地 サルモネラシゲラの選択分離培養 100枚入 極東製薬工業 型番 05440 JAN 4987551054408 aso 2-6351-02 ●在庫品 納期約 6営業日-【医療・研究機器】

栄研化学 E-MA85 粉末培地(ボトル顆粒) パールコア(R) DHL寒天培地

株式会社サンユー・埼玉県・飯能市・医療・試薬・消毒・日水製薬・栄研化学

マッコンキー寒天培地試薬 MacConkey Sorbitol Agar微生物学用大腸菌群大腸菌

寒天培地 寒天培地,培地,寒天,平板培地,ディスポループ,白金耳,微生物実験,培養,細菌,研究室の写真素材

★ポイント最大16倍★【全国配送可】-粉末培地(分包顆粒) パールコア(R) DHL寒天培地 10袋入 栄研化学 型番 E-KA20 JAN 4987026158938 aso…

栄研化学 E-MA85 粉末培地(ボトル顆粒) パールコア(R) DHL寒天培地

フリーワード出版年疾患・領域疾患・領域診療科目診療科目媒体媒体記事体裁大腸菌フリーワード出版年疾患・領域疾患・領域診療科目診療科目媒体媒体記事体裁M-Review関連サイトサービス

ベクトン・ディッキンソン BD BBL(TM) TSA5%ヒツジ血液寒天培地/DHL寒天培地 100枚 1個(1本×100枚入) 252022

BD BBL TM 変法サルモネラ・シゲラ寒天培地/CT-ソルビトール添加マッコンキーU寒天培地 LDIP 100枚

ベクトン・ディッキンソン 212087 BD BBL(TM) DHL寒天培地 20枚

ベクトン・ディッキンソン 212087 BD BBL(TM) DHL寒天培地 20枚

Incident ID: 650b71e3-bohn-45d6-93be-f3039f81deda IP Address : 219.104.25.38
★ポイント最大16倍★【全国配送可】-生培地(バイタルメディア) DHL寒天培地 サルモネラシゲラの選択分離培養 100枚入 極東製薬工業 型番 05440 JAN 4987551054408…

2-6430-10 ぺたんチェック(R)10 SCD寒天培地 PT8010

未分類 暇をみてNO①寒天培地を作ってみました。 おすすめこのサイトについて

生培地 (バイタルメディア) DHL寒天培地 サルモネラシゲラの選択分離培養 20枚入 05441

環境微生物学研究室 - 近畿大学生命科学科 環境微生物学研究室の紹介 EGU(欧州地球科学連合)2023年総会での口頭発表 牧教授おすすめ書籍その⑧ 『海洋化学研究』最新版に原稿掲載 黄砂サンプリング:牧レポート(京都) 黄砂サンプリング:牧レポート(大阪上空) 本日(4/13)の産経新聞にコメント掲載 能登での上空サンプリング

栄研化学 ぺたんチェック®DD MYP寒天培地 PD0017(20枚)

Incident ID: 48b4529d-bohn-4ba7-ad40-4000ab548cba IP Address : 219.104.25.38

栄研化学 粉末培地(分包顆粒) パールコアR DHL寒天培地 10袋入 E-KA20 1箱(10袋入)

Incident ID: 7790e167-bohn-43d6-a4d8-9dac518789c6 IP Address : 219.104.25.38

Incident ID: 2498ab02-bohn-4c55-882a-da94c7a8a941 IP Address : 219.104.25.38

島津ダイアグノスティクス DHL寒天培地(顆粒)300g入 05040 1個(300g入)

Incident ID: dd26f21a-bohn-4872-97d3-dd8dec3ded73 IP Address : 219.104.25.38

Incident ID: 129734af-bohn-487d-8417-4c4a81688e48 IP Address : 219.104.25.38

株式会社サンユー・埼玉県・飯能市・医療・試薬・消毒・日水製薬・栄研化学

ベクトン・ディッキンソン BD BBL(TM) DHL寒天培地 100枚 1個(1本×100枚入) 251250

Incident ID: b7b3a869-bohn-4e9c-a192-d005b4995178 IP Address : 219.104.25.38

島津ダイアグノスティクス 5040 アキュディア DHL寒天培地(顆粒)300g入

Incident ID: d3e4975a-bohn-469b-b084-abe5e971e535 IP Address : 219.104.25.38

★ポイント最大16倍★【全国配送可】-生培地(バイタルメディア) DHL寒天培地 サルモネラシゲラの選択分離培養 20枚入 極東製薬工業 型番 05441 JAN 4987551054415…

Incident ID: 12544f9f-bohn-476d-b37f-4739c8face47 IP Address : 219.104.25.38

アスクルケニス 分包培地デオキシコレート寒天培地 717702-4 33620312 1箱(40袋入)(直送品)